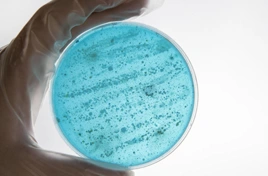
Legionella

sales@corrosionprotectionsystems.co.uk
Units 2 & 3 Lockskinners Farm Chiddingstone Kent TN8 7NA
sales@corrosionprotectionsystems.co.uk
Units 2 & 3 Lockskinners Farm Chiddingstone Kent TN8 7NA

CPS Management Services design, construct & maintain all types of water features
Legionnaires’ disease was first identified in 1976 following a large outbreak of a pneumonia type...

Whatever type of water you need testing, whether it be from a borehole, a swimming pool, a mains water tap ...

For whatever type of water system you need treating, we have the correct type of treatment for you

With over 35 years experience in the field of water treatment and maintenance

CPS work with companies who operate in the many areas of water treatment. We supply, install & maintain water tanks

Aqua-lid is a range of bespoke GRP lids or covers which are manufactured in-house. Legislation within the water industry, specifically...

An extremely strong and durable material, liquid in application, which can be formed to all manner of profiles for waterproofing..

From ensuring a seamless and strong lining for a wet room, to installing a durable glass fibre roof or refurbishing a water tank ...

Fibre-Roof is a GRP system, used to provide a completely weatherproof surface for flat roofing, eliminating many of the problems associated with...

We supply and deliver all GRP related materials. Prices on request, VAT applicable. We can supply a complete kit based on quoted..
CPS Management Services Ltd are experts in designing, constructing and maintaining water features. With extensive knowledge and experience, we work closely with Commercial Developers, Local Councils and Landscape Architects, to achieve the desired concept.
We offer a wide range of Glass Reinforced Plastic (GRP) products and services, from tank lids to lining roofs, ponds, wet rooms etc.
Our Water Hygiene department carries out routine water testing, disinfections and Legionella Risk Assessments for both individuals and commercial properties.

